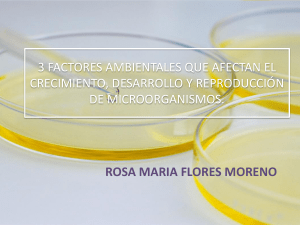
FACTORES AMBIENTALES inds

Clostridium botulinum

Clostridium botulinum es el nombre de una especie de bacilo (Gram positiva anaerobia) que se encuentra por lo general en la tierra y es productora de la toxina botulínica, el agente causal del botulismo. Estos microorganismos tienen forma de varilla y se desarrollan mejor en condiciones de poco oxígeno. Las bacterias forman esporas que les permiten sobrevivir en un estado latente hasta ser expuestas a condiciones que puedan sostener su crecimiento. La espora es ovalada subterminal y deformante. Es móvil por flagelos peritricos, no produce cápsula y es proteolítico y lipolítico. Son miembros del género Clostridium. Uno de los grupos más numerosos entre las formas Gram positivas (C. botulinum) fue descubierta y aislada en 1896 por Emile van Ermengem.Hay ocho tipos de toxinas botulínicas designadas por las letras A hasta la H; sólo los Clostridium botulinum es un organismo de agua de un grado de salinización alto, sus esporas pueden sobrevivir en la mayoría de los ambientes y son difíciles de destruir incluso a la temperatura de ebullición del agua a nivel del mar, de modo que muchos enlatados son hervidos a altas presiones para destruir las esporas.El botulismo es una enfermedad de declaración obligatoria. Puede aparecer en cualquier alimento de origen animal o vegetal, siendo las conservas, especialmente las caseras, los lugares donde aparece en la práctica totalidad de los brotes. Las latas de conserva deformadas que sueltan gas al abrirse es más que probable que estén contaminadas por C botulinum. Con los ahumados y las especias se puede enmascarar el mal olor.El crecimiento de la bacteria puede ser prevenido con acidez, una alta concentración de azúcar disuelto, altos niveles de oxígeno o poca humedad. Un medio de baja acidez, como por ejemplo los vegetales enlatados como las judías verdes, que no hayan sido calentados lo suficiente para destruir las esporas, puede proveer un medio libre de oxígeno que le permita a las esporas crecer y producir la toxina. Por el contrario, los tomates o salsas si son suficientemente ácidos pueden prevenir crecimientos, aún si las esporas estuviesen presentes, por tanto no presentan peligros para los consumidores. La miel, el jarabe de maíz y otros aditivos dulces pueden contener las esporas de C botulinum, pero las esporas no pueden crecer en soluciones con tan altas concentraciones de azúcares; sin embargo, cuando el azúcar es diluido en el ambiente de bajo oxígeno y baja concentración como puede ser el jugo gástrico de un infante, las esporas pueden desarrollarse y producir la toxina. Tan pronto como los recién nacidos comienzan a consumir alimentos sólidos, el ácido gástrico es suficiente para impedir el crecimiento de la bacteria. En neonatos, la enfermedad puede ser secundaria a la colonización del colon por Clostridium botulinum.